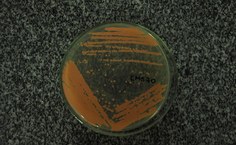
Placa com cultura de microorganismos coletados

2
Projeto busca fortalecer identidade cultural do Mercado do Artesanato de Maceió
Ação faz parte do Proinart e envolve estudantes de Relações Públicas, Jornalismo, Design e Teatro
- Atualizado em

Simoneide Araújo – jornalista colaboradora
Mercado Público do Artesanato: retrato da cultura, identidade e patrimônio de Alagoas. Esse é o tema do projeto de extensão inscrito noPrograma de Iniciação Artística (Proinart) da Universidade Federal de Alagoas. A proposta é fortalecer a identidade cultural do Mercado, para que a comunidade local e os visitantes conheçam o lugar, uma vez que onde ele está instalado não tem um bom acesso e está fora da rota turística. O que se quer é difundir as atividades desenvolvidas pelos artesãos e a arte genuinamente alagoana.
O projeto tem a participação dos estudantes Érica Rocha, Jéssica Roberta e Luan Soares, do curso de Relações Públicas; Cláudia Leite e Mailson Honorato, de Jornalismo; Joesile Cordeiro, de Tetaro; e Pedro Lopes, de Design. A coordenação é da professora Sandra Nunes, do Departamento de Comunicação Social, coordenadora do curso de Relações Públicas.
De acordo com Érica Rocha, uma das idealizadoras do projeto, a proposta é consolidar o sentimento de pertencimento de quem trabalha no Mercado do Artesanato. “Estamos trabalhando junto com os artesãos para saber as demandas deles, vamos entregar um plano de comunicação, incluindo a inserção do local nas redes sociais Facebook e Instagram, porque os artesãos querem projetos que viabilizem a ida de turistas e da comunidade local. Essa é uma questão imediata para eles: levar turistas para o Mercado”, disse.
Iniciado em agosto de 2016, o projeto vai iniciar a segunda fase que é criar a identidade do local, uma marca e promover palestras para artesãos, enfocando seu papel e seus valores para a sociedade alagoana; levar apresentações de espetáculos de teatro de objetos em escolas públicas municipais, no Espaço Quintal Cultural, de Bom Parto, e em instituição que abriga crianças carentes, localizada no Tabuleiro do Martins, próximo à Ufal. “Estamos preparando um documentário e exposição fotográfica. Já passamos pela primeira etapa, que foi planejamento e levantamento de informações. A partir dessas informações, estamos elaborando o espetáculo de teatro de objetos, que usará os produtos produzidos no próprio Mercado, transformados em personagens na cena”, completou Érica.
A previsão de conclusão do projeto é junho desse ano, quando será elaborado artigo científico sobre a situação encontrada no Mercado de Artesanato, o que foi feito pelo projeto, identificando quem produz, de fato, o artesanato genuinamente alagoano. “Esse é um requisito exigido pelo Proinart”, destacou Érica.
Projeto Clinamen promove palestra sobre ceticismo
Evento será nesta quarta-feira (22), às 18h
- Atualizado em
Ascom Ufal
O professor de Filosofia da rede estadual de ensino e estudante de Especialização em Filosofia Contemporânea na Ufal, Denis Ricardo da Silva, fará uma palestra sobre a temática “Apontamentos Pragmáticos do Ceticismo, Apontamentos Céticos em o 'Da Certeza'”.
Os interessados em participar devem comparecer no miniauditório do curso de filosofia, sala 06, às 18 horas, nesta quarta-feira (22).
A palestra é promovida pela Coordenação do Projeto de Extensão Clinamen, em parceria com a Coordenação do Curso de Filosofia.
Proex divulga resultado da seleção para as Casas de Cultura
Lista de aprovados foi publicada hoje; aulas começam na segunda
- Atualizado em
Ascom Ufal
O resultado da seleção para os cursos de idiomas oferecidos pelas Casas de Cultura foi divulgado no final da tarde de hoje, pela Pró-reitoria de Extensão (Proex) e pela Faculdade de Letras da Universidade Federal de Alagoas (Fale/UFAL). Ao todo, foram disponibilizadas 820 vagas para os cursos de alemão, espanhol, francês, inglês, português e libras, sendo 20 vagas por turma. Conforme consta no edital n. 3/17 , as aulas já começam na próxima segunda-feira, 13.
Os cursos das Casas de Cultura são projetos de extensão da Faculdade de Letras, que compõem um programa apoiado pela Proex, e têm como objetivo o estímulo à difusão das línguas alemã, espanhola, francesa, inglesa, portuguesa e da língua brasileira de sinais (Libras) e suas expressões culturais.
Confira o resultado aqui.
http://www.ufal.edu.br/utilidades/concursos-e-editais/extensao/casas-de-cultura-2013-espaco-cultural
Revista de turismo ganha mais uma edição e recebe artigos de pesquisadores
Submissão na Ritur é em fluxo contínuo; Revista passa a ser quadrimestral
- Atualizado em

Ascom Ufal
A Revista Iberoamericana de Turismo (Ritur), única da Ufal com conceito B1 de classificação Qualis da Capes, terá uma edição a mais por ano, tornando-se quadrimestral. Os artigos são recebidos para avaliação em fluxo contínuo por meio de cadastro no site do periódico.
O último número, de dezembro de 2016 foi publicado com nove artigos, um ensaio, uma resenha bibliográfica e um texto na seção ‘Ponto de Vista’ sobre os legados da Copa do Mundo de Futebol para o desenvolvimento do turismo sustentável. O editorial é assinado pela professora da Ufal Silvana Pirillo Ramos e o professor espanhol Lluís Mundet i Cerdan, co-editor científico.
Confira aqui a edição v.2 n. 2 (2016).
A Ritur nasceu em 2011 e é a única revista internacional com participação da Universidade Federal de Alagoas. Também fazem parte do comitê editorial os professores Alan Curcino Pedreira da Silva (Ufal) e Luciana Ferreira da Costa (UFPB).
O periódico é uma iniciativa do Observatório Transdisciplinar de Pesquisas em Turismo da Ufal e da Facultat de Turisme de la Universitat de Girona (Espanha), criada por meio do convênio de cooperação internacional de pesquisa e desenvolvimento em Turismo entre estas instituições, com o apoio da Agencia Española de Cooperación Internacional para el Desarrollo.
A Ritur passou a contar com a colaboração da Rede de Pesquisa e (In)Formação em Museologia e Patrimônio da Universidade Federal da Paraíba (Brasil) e do Centro de Estudos de História e Filosofia da Ciência da Universidade de Évora (Portugal) a partir da publicação do seu primeiro número especial.
De acordo com o comitê editorial, a revista tem por objetivo “divulgar trabalhos que representam contribuição para o desenvolvimento de novos conhecimentos entre pesquisadores, docentes, discentes e profissionais em turismo, hospitalidade, museologia e patrimônio, História, Geografia, lazer e áreas afins, independente de sua vinculação profissional e local de origem, priorizando diálogos abertos e abordagens interdisciplinares a transdisciplinares”.
Com indexação internacional, a RITUR disponibiliza seu conteúdo de modo gratuito, sem cobrança para publicação de trabalhos originais.
Revista do Cedu publica dossiê sobre Base Nacional Comum Curricular
Última edição do periódico traz artigos que problematizam o documento do MEC e manifesto do Fórum Paulista de Educação Infantil
- Atualizado em

Manuella Soares - jornalista
O assunto mobiliza o sistema educacional do país. E para entrar no debate sobre a Base Nacional Comum Curricular (BNCC), a revista do Programa de Pós-graduação em Educação da Ufal publicou um dossiê eletrônico que reúne artigos de vários pesquisadores. A proposta de construir uma BNCC no Brasil seria um descritivo de conteúdos e saberes necessários para cada ano e segmento da Educação Básica. Mas essas orientações têm causado divergentes opiniões.
Intitulado Educação Infantil e Base Nacional Comum Curricular : questões para o debate, o dossiê é organizado pelos professores do Centro de Educação da Ufal (Cedu) Cleriston Izidro dos Anjos e Solange Estanislau dos Santos, que assinam o editorial da revista.
A nova edição do periódico eletrônico conta com uma entrevista com a professora Rita Coelho, que esteve à frente da Coordenação Geral de Educação Infantil do MEC, além de nove artigos de pesquisadores de instituições como USP, Unicamp, UFSCar, Uerj, UFC, UFRGS, Unisinos, Unesp, UEL, Unirio e Unisul. A revista encerra com um Manifesto Indignado produzido pelo Fórum Paulista de Educação Infantil.
A BNCC vem sendo discutida com mais ênfase desde o final de 2015 e, no ano passado, quando houve uma consulta pública do documento preliminar. Depois disso, foi publicada a segunda versão incluindo as contribuições de pesquisadores, formadores de professores e representantes de associações lidas à educação. De acordo com o professor Cleriston, é importante problematizar, antes do texto final do MEC, o que está sendo proposto para a educação infantil e a legitimidade de uma Base Nacional.
“Em que medida as crianças estão sendo consideradas na BNCC? O que já temos de produção escrita sobre a BNCC que pode contribuir para alimentar o debate a respeito da proposta? As crianças precisam de uma BNCC? As especificidades da educação infantil estão sendo respeitadas? Os marcadores de diferenças - raça, etnia, religião, sexualidade, classe social - estão devidamente referenciados e contemplados? O que tem em comum todas as crianças brasileiras? Que projeto de nação está fundamentando as propostas?”, questiona o professor.
Essas inquietações impulsionaram a organização do Dossiê que pretende fomentar o debate de uma proposta que está em processo de elaboração num contexto de instabilidade política.
“A tentativa foi de aglutinar nesse espaço todos os setores que lutam, pesquisam e vivem a educação infantil pública, e buscam a legitimação da elaboração de políticas públicas com participação da sociedade civil, dos movimentos sociais e da universidade”, explica Cleriston.
Os organizadores do periódico deixam uma mensagem de reflexão. “Esperamos que o conjunto de reflexões contribua para questionarmos o porquê, o para quê e a serviço de quem está a proposta da BNCC. Que uma BNCC não apague o que há de extraordinário nas crianças e no cotidiano das creches e pré-escolas brasileiras. Que as contribuições de cada um dos artigos possam alimentar o debate e nos fortalecer nestes tempos difíceis que vivemos, e impulsionem a luta em defesa da Educação Infantil pública, gratuita, laica e de qualidade para todas as crianças”, assinam os professores Cleriston e Solange.
Confira aqui o Dossiê publicado na revista Debates em Educação.
Revista do curso de Arquitetura recebe artigos para submissão
Com periodicidade anual, a Revista Ímpeto tem como foco para 2017 artigos relacionados à arquitetura e à cidade
- Atualizado em

Diana Monteiro - jornalista
Até o dia 2 de abril, o Programa de Educação Tutorial (PET), do curso de Arquitetura, recebe artigos acadêmicos, para submissão, que irão compor a 7ª edição da Revista Ímpeto, de periodicidade anual. O título da próxima edição será Vivacidade: desafios, planejamento e participação. Nesse contexto, a proposta do informativo para 2017 é contemplar artigos relacionados à arquitetura e à cidade.
Conforme os organizadores, a revista propõe debater sobre a cidade contemplando seus desafios, ações possíveis de planejamento e a importância da participação do cidadão. O debate visa promover discussões sobre o papel do arquiteto face às interferências que o urbanismo e a arquitetura podem provocar na dinâmica social do espaço urbano e como as diversas intervenções podem contribuir para a identificação e envolvimento do usuário que o vivencia, inspirando a construção de ideias e alternativas para o planejamento de cidades mais vivas.
Mais informações sobre a Revista Ímpeto e artigos acesse aqui ou envie suas dúvidas para o e-mail: revistaimpeto@gmail.com .
Revista Musifal publicará artigos apresentados em jornada acadêmica
Lançamento da terceira edição está previsto para segundo semestre desse ano
- Atualizado em

Simoneide Araujo – jornalista colaboradora
Após passar por uma reestruturação para atender aos padrões do Sistema Eletrônico de Editoração de Revistas (SEER) da Universidade Federal de Alagoas, a terceira edição da revista Musifal será lançada no segundo semestre de 2017. Esse próximo número está recheado de artigos científicos de pesquisadores de vários estados, que foram apresentados durante a 7ª Jornada Pedagógica para Músicos de Banda, realizada em novembro de 2016, na cidade de Marechal Deodoro-AL.
A Musifal é um projeto registrado na Pró-reitoria e Extensão e tem como proposta apresentar o que vem sendo estudado e pesquisado na área de Música em Alagoas e no Nordeste brasileiro, numa linha que vai da Musicologia à Educação Musical. Editada desde 2010, a Musifal é a segunda revista eletrônica da Universidade e, de acordo com Marcos Moreira, coordenador do curso de licenciatura em Música da Ufal, até a edição de 2011, a revista não estava nos padrões de uma publicação científica, era apenas um “depósito” de artigos.
“Mesmo assim, conseguimos apresentá-la em eventos no Rio de Janeiro, São Paulo e Portugal, porque queríamos mostrar que, mesmo sem ter uma estrutura mínima para se trabalhar e desenvolver pesquisa, produzimos muito. A revista, como estava, serviu como um apoio de registros científicos de eventos acadêmicos. Agora é muito mais que isso”, ressaltou.
Marcos Moreira e mais dois professores do curso de Música, Flávio Ferreira e Milson Fireman, estão na comissão organizadora. “Já temos grandes pesquisadores doutores que estão na Comissão Editorial: Diana Santos, Joel Barbosa e Celson Benedito, da Ufba [Universidade Federal da Bahia]; Marco Toledo, da UFC [Universidade Federal do Ceará]; Diósnio Neto, da USP; e Alexandre Andrade, Instituto Piaget, de Portugal”, disse Moreira.
A terceira edição, já no novo formato dentro do SEER, onde há vários outras publicações científicas da Ufal, também será apresentada na 8ª Jornada Pedagógica para Músicos de Banda, que já está no calendário de eventos de Marechal Deodoro e acontece no final desse ano. “A partir da edição de 2018, nossa revista publicará artigos inscritos na Jornada e também passará a publicar os artigos do Simpósio da Associação Brasileira de Musicologia, que fará parceria permanente com a Jornada Pedagógica”, completou Moreira.
Essa parceria, segundo o professor, dará mais notoriedade à revista e numa dimensão muito mais abrangente. “Vamos ser uma ramificação do simpósio com a temática bandas de música. Com isso, nossa revista vai ampliar o alcance e terá ramificações no meio científico onde mais se produz pesquisa na área de música – São Paulo, Rio de Janeiro e Rio Grande do Sul. Para nós é um crescimento muito grande”, completou.
Seminário reúne cerca de 400 alfabetizadores na Ufal
Educadores de todo o Estado participaram do encerramento da edição 2016 do Pacto Nacional pela Alfabetização na Idade Certa
- Atualizado em

Lenilda Luna - jornalista
Alfabetizadores das redes municipais dos 102 municípios alagoanos e representantes da Secretaria Estadual de Educação participaram do Seminário de Encerramento do Pacto Nacional pela Alfabetização na Idade Certa (Pnaic/2016), nesta terça-feira (14). O Pacto foi lançado em 2013 pelo Ministério da Educação (MEC) para garantir a alfabetização de estudantes de até oito anos de idade, do 1º ao 3º anos do ensino fundamental.
Em Alagoas, no primeiro ano, a formação dos professores foi coordenada pela Universidade Federal de Pernambuco, mas já em 2014 passou para a responsabilidade do Centro de Educação (Cedu) da Ufal. Atualmente o programa de formação de alfabetizadores é coordenado pelo professor Elton Casado Fireman.
Constatou-se que nas regiões Norte e Nordeste chega a 35% o percentual de crianças que não sabem ler e nem escrever nessa faixa etária e nesses anos escolares. "Realizamos a formação de orientadores de estudos, que participam da capacitação dos alfabetizadores nos polos e municípios. É uma rede que alcança cerca de nove mil professores e impacta na educação de cerca de 180 mil crianças em Alagoas", ressalta Elton.
A importância social e pedagógica do Pnaic ganha ainda mais relevância diante dos índices ainda baixos da educação básica no Estado. "Percebemos que as escolas municipais de Alagoas já melhoraram na avaliação do Ideb [Índice de Desenvolvimento da Educação Básica], mas temos ainda muitos desafios a serem superados. O ano passado foi particularmente difícil por causa da turbulência política e a expectativa da continuidade do Pacto. Mas estamos concluindo essa turma e já temos a previsão de selecionar mais professores a partir de abril ou maio", informou.
Entre os cerca de 400 professores que lotaram dois auditórios na Ufal, a alfabetizadora Araly Batista, da Escola Paulo Freire, localizada no Sítio São Jorge, em Maceió, elogiou o programa. "Como orientadora de estudos e como professora alfabetizadora, aprendi muito nas oficinas de prática de leitura e de escrita e nos estudos sobre a relação entre teoria e prática na sala de aula. Também tivemos uma rica troca de experiências com alfabetizadores de todas as regiões do estado", destacou Araly.
Já o professor Erivaldo Valério, que atua na Secretaria Municipal de São José da Laje, na zona da mata alagoana, ressaltou o compartilhamento de pesquisas. "Foi importante conhecer quais as pesquisas e estudos mais recentes em alfabetização, promovidos nas universidades federais, para poder levar esse conhecimento para nosso município", declarou o educador.
Seminários marcam início do processo avaliativo da expansão e interiorização da Ufal
Comunidades universitárias dos três campi da Universidade foram envolvidas no projeto de avaliação
- Atualizado em

Ascom Ufal
Após apresentação nos campi da Ufal em Arapiraca e Delmiro Gouveia, o Seminário de Avaliação da Expansão e Interiorização da Universidade Federal de Alagoas foi realizado na tarde dessa quinta-feira (23), no auditório do Campus A. C. Simões.
A reitora Valéria Correia, o vice José Vieira e demais membros da comunidade universitária participaram do evento. “Iniciamos, efetivamente, esse processo de avaliação e, ao longo do processo, serão realizadas demais atividades, a exemplo de oficinas e audiências públicas”, destacou a reitora ao lembrar que os dados avaliativos serão utilizados para elaboração do Plano de Desenvolvimento Institucional (PDI) da Ufal.
“Contamos com uma equipe executiva bastante comprometida e convidamos a todos a se engajarem neste momento para que se possa pensar a Ufal que sonhamos e que se quer construir nos próximos anos”, destacou José Vieira, responsável pela coordenação-geral dos trabalhos de avaliação.
A palestra do pesquisador Luís Henrique Romani de Campos, da Fundação Joaquim Nabuco, intitulada A interiorização recente das universidades federais no Nordeste: efeitos e mudanças, direcionou os debates com o público presente. A professora do curso de Serviço Social do Campus A. C. Simões, Sueli Maria do Nascimento, foi a outra palestrante do dia que trouxe contribuições sobre o assunto da interiorização do ensino superior.
Campos destacou que o foco deve sempre estar na busca por conhecer os efeitos que a presença da Ufal produziu, principalmente, no âmbito da construção do capital social e humano. "Avaliar, de forma comprometida, implica mudar e inovar a própria gestão da universidade, de modo que ela dialogue ainda mais com a sociedade, comprometendo-a em seu papel social", ressaltou.
Os docentes Danielle da Nóbrega, da Unidade de Ensino de Palmeira dos Índios, Fabiano Santana, do Campus Arapiraca, e Sueli Maria do Nascimento deram visibilidade à expansão do ensino superior público em Alagoas a partir de 2005, identificando traços da expansão no Brasil inspirados em processos internacionais, como o Protocolo de Bologna e o projeto Universidade Nova.
Eles ainda destacaram que o significado da interiorização para os estudantes também é de oportunidades, o que compromete toda a Comunidade da Ufal e a sociedade alagoana com a necessidade de lutar para que as unidades fora de sede tenham condições de funcionamento, de forma a assegurar a formação pública, gratuita e de qualidade.
Segundo a coordenadora executiva do projeto, professora Mailiz Garibotti Lusa, um relatório parcial sobre o processo avaliativo já será publicado em junho ou julho, e a conclusão está prevista para os meses de outubro ou novembro de 2017. “Será um trabalho amplo de avaliação e que necessita da colaboração de todos os que fazem parte da Ufal para que o processo seja participativo, democrático e transparente. É um momento para consolidar a luta pela garantia do direito à educação”, afirmou Mailiz.
Nos três seminários foi apresentada pela Comissão Executiva de Avaliação o desenho metodológico do processo, que começará a ser implantado entre março e abril deste ano.
Técnicos e docentes devem votar nos representantes para a CPA
A votação é online pelo sistema da Ufal
- Atualizado em

A Universidade Federal de Alagoas está renovando os integrantes da Comissão Própria de Avaliação. As eleições se dão da seguinte forma: o técnico vota no candidato técnico do campus onde está lotado. Assim também com os docentes, que votam no candidato do respectivo campus. No Sertão, não houve inscrição de candidato. No Campus A.C. Simões, a votação se divide por área de Humanas e Sociais, Exatas e Naturais e Ciências da Saúde.
O link para a votação estará disponível no dia da eleição, que acontecerá da meia noite do dia 21 de fevereiro até às 23h59 do dia 22. O usuário precisará colocar login e senha para ter acesso ao sistema e depois votar nos candidatos inscritos. É muito importante a participação de todos, para referendar os nomes que se dispuseram a colaborar com a Comissão. A avaliação interna é um dos instrumentos do Sistema Nacional de Avaliação da Educação Superior (Sinaes) e tem como objetivo consultar a comunidade acadêmica para fazer o levantamento de informações que permitam identificar potencialidades e fragilidades da instituição.
A Comissão Própria de Avaliação (CPA) é responsável pela condução do processo avaliativo, sistematização dos dados e repasse ao público interno e externo. A CPA da Ufal é formada por representantes docentes, técnicos-administrativos e discentes dos campi A. C. Simões, Arapiraca e Sertão, além de membros da sociedade.
Trabalho de professor sobre Zika foi escolhido em edital do Conselho Britânico
Parceria entre Alagoas e Reino Unido vai financiar R$ 400 mil para a pesquisa
- Atualizado em

Ascom Ufal com colaboração de Ascom Fapeal
O trabalho de um pesquisador da Ufal foi selecionado num edital do Conselho Britânico para financiar pesquisas sobre o Zika vírus. O professor Baldoíno Fonseca, doutor em informática do Instituto de Computação (IC) irá desenvolver seu trabalho em parceria com o pesquisador Alexander Romanovsky, ligado à Universidade de Newcastle, no Reino Unido.
A colaboração também vai contar com pesquisadores da Universidade Federal de Pernambuco, da Fundação Oswaldo Cruz e da Pontifícia Universidade Católica, no Rio Janeiro. A Fundação de Amparo à Pesquisa do Estado de Alagoas (Fapeal) destinou R$215 mil para cooperação de pesquisa entre Alagoas e o Reino Unido.
O recurso é a contrapartida do Governo de Alagoas à chamada que lançou até 100 mil libras para estudos sobre a doença, por meio do Newton Fund, uma iniciativa do governo britânico que destina recursos para pesquisa, ciência e tecnologia em países parceiros.
Isto significa que o investimento total no projeto aprovado vai ultrapassar os R$400 mil, em 36 meses.
Além de Alagoas, outros quatro estados brasileiros emplacaram suas propostas: Pernambuco, Paraíba, Rio de Janeiro e Distrito Federal. O resultado nacional foi divulgado pelo Conselho Britânico e pode ser acessado aqui.
Sobre o estudo
O título da pesquisa é Combinando gamificação e redes sociais para melhorar a prevenção e controle do Zika. Além de entrevistas com as comunidades locais, a ideia lança mão das informações postadas por essas pessoas em aplicativos e redes sociais sobre focos de vírus, suspeitas da doença e casos confirmados.
Aliando a participação comunitária à tecnologia, o projeto também visa desenvolver recursos voltados à inteligência de dados, como softwares, mapas-online e algoritmos.
Tudo isso é num esforço de mapear a incidência do Zika vírus, identificar seus padrões de incidência e analisar a previsibilidade dos focos.
“Nosso objetivo é o de prever locais e atuar com antecedência”, declara Baldoíno Fonseca. “A colaboração com o Reino Unido é importante por causa do know-how que os pesquisadores de lá já têm”, comenta o pesquisador, referindo-se aos aspectos técnicos da iniciativa.
Trabalhos acadêmicos poderão ser redigidos em outros idiomas além do Português
Proposta da Propep foi aprovada na sessão ordinária do Consuni
- Atualizado em

Ufal e Prefeitura de Delmiro Gouveia planejam soluções para transporte de estudantes
A Gestão da Ufal está visitando as prefeituras para firmar convênios de cooperação técnico- científica e discutir a mobilidade estudantil
- Atualizado em

Jacqueline Freire – jornalista colaboradora
O vice-reitor da Universidade Federal de Alagoas, José Vieira Cruz, e as pró-reitoras de Graduação e Estudantil, Sandra Regina Paz e Silvana Medeiros, estiveram na última quarta-feira ( 22), em reunião com o chefe de gabinete da Prefeitura de Delmiro Gouveia e sua equipe para tratar de questões sobre o transporte estudantil do município para a Universidade. Além disso, cumprindo uma agenda de aproximação institucional, os gestores propuseram convênios e parcerias para cooperação técnico-científica.
De acordo com os gestores, muitos estudantes deixaram de ir para as aulas por falta de transporte, impactando no desempenho acadêmico e causando evasão. Durante a reunião, o vice-reitor da Ufal apresentou outros pontos importantes, como o estabelecimento de parceria para definição da política de estágio curricular e não obrigatório; a oferta de cursos, assessorias e desenvolvimento de projetos acadêmicos; o restabelecimento da parceria com a cessão de técnicos da prefeitura para apoiar nas ações da Editora Universitária no campus e na biblioteca.
A Prefeitura de Delmiro se comprometeu em avaliar a situação e realizar uma parceria com a Ufal para composição do Fórum Local de Gestão Pública na cidade; além da elaboração de um convênio guarda-chuva entre a Universidade e a Prefeitura para desenvolvimento de inúmeros projetos acadêmicos com foco no ensino, pesquisa, extensão e política de estágio.
Segundo Vieira, a reunião foi produtiva. “Percebemos o desejo de todos de contribuírem para gestão pública do município e melhoria da qualidade de vida da população universitária de Delmiro Gouveia, além de desejar uma excelente gestão, que já anuncia que será muito dinâmica, participativa e democrática. Nós da gestão da Ufal nos colocamos a disposição para colaborar”, ressaltou o vice-reitor.
Reunião com prefeito de Maceió
Os gestores da Ufal têm realizado uma agenda de reuniões em busca de parcerias com as prefeituras. O vice-reitor José Vieira também se reuniu, no dia 17, com o prefeito de Maceió, Rui Palmeira, e a chefe de gabinete da Prefeitura, Juliana Vergetti, para tratar, entre outros assuntos, da realização da Bienal do Livro 2017 e o encontro da Sociedade Brasileira para o Progresso da Ciência (SBPC) que acontece em Maceió em 2018.
Para Vieira, a reunião foi bastante significativa. “A equipe de gestão da prefeitura e o prefeito Rui Palmeira, acolheu a pauta apresentando o interesse de realizar um trabalho colaborativo com a Ufal, a instituição pública do Estado e que está aberto, e toda sua equipe, para realizar importantes trabalhos de parceira”.
A pauta da reunião teve como lema Construindo laços de trabalho e cidadania. Também foram discutidas possíveis parcerias para estágios curriculares e não obrigatórios, mobilidade estudantil para os estudantes de Viçosa e melhoria da oferta e qualidade do transporte, especialmente para o turno noturno; Casa de Cultura para professores e estudantes; construção de complexo esportivo e centros urbanos; construção de clínica odontológica da Faculdade de Odontologia e Empresa Júnior de Agrimensura.
Estiveram presentes na reunião, representantes da Superintendência Municipal de Transportes e Trânsito (SMTT), da Secretaria Municipal de Assistência Social (Semas), da Secretaria Municial de Saúde (SMS) e da Secretaria Municipal de Educação (Semed).
Ufal integra Plataforma Zebrafish do Instituto Butantan
Plataforma proporciona a implantação de um biotério com capacidade para criar até três mil peixes adultos
- Atualizado em

Diana Monteiro - jornalista
Um seminário realizado na manhã desta quinta-feira (23) marcou mais uma etapa da fase de implantação da Plataforma Zebrafish, do Instituto Butantã - São Paulo, na Universidade Federal de Alagoas. A atividade, ministrada pela diretora do Laboratório Especial de Toxinologia Aplicada do citado Instituto, Mônica Lopes, no auditório do antigo Csau, no Campus A. C. Simões, contou com a participação de alunos de diversas áreas, especialmente, Ciências Biológicas, Farmácia e Agrárias.
O evento contou também com a participação da diretora do Instituto de Ciências Biológicas e da Saúde (ICBS), Iracilda Moura, e do representante da Pró-reitoria de Pesquisa e Pós-graduação (Propep), André Lage.
A Ufal passa a integrar a Rede Zebrasfish com outros centros de pesquisa, o que vai proporcionar a instalação de um biotério com capacidade para criar até três mil peixes adultos do tipo paulistinha, também conhecido como zebrafish. Possibilitará ainda a realização de pesquisas na área de saúde, cuja espécie tem sido usada como modelo em pesquisas científicas.
A coordenadora da Rede e responsável pelo Centro de Toxinas, Resposta Imune e Sinalização Celular do Centro de Pesquisa, Inovação e Difusão (CeTICS), Mônica Lopes, destacou os avanços dos estudos científicos no Brasil e no mundo utilizando a espécie Zebrafish, que chegam a ultrapassar mais de três mil publicações de artigos. Informou que o primeiro artigo sobre a espécie foi publicado em 1981 pelo pesquisador George Streisenger, considerado o introdutor do peixe como modelo de animal para pesquisa científica pesquisa; já no Brasil, a primeira publicação sobre o assunto foi em 2014.
Ela enfatizou que são inúmeros os livros sobre estudos com a espécie para aplicação em diversas áreas. No Brasil, o estado que mais se destaca em publicações é o Rio Grande do Sul. “Fazem ainda pesquisa utilizando a espécie os estados de São Paulo, Rio de Janeiro, Minas Gerais, Santa Catarina, Distrito Federal (Brasília), Amazonas, Pará, Ceará e, agora, chegou a vez de Alagoas por meio da Ufal”, diz Mônica.
Alavancar pesquisas
Espécie bastante conhecida, por ser facilmente criada em aquário, o Zebrafish é nativo do Sul da Ásia e encontrado em rios calmos e rasos e nas plantações de arroz e juta. A espécie alimenta-se de uma ampla variedade de zooplâncton, insetos, algas e outros materiais orgânicos e não gosta viver sozinha. O tempo de vida é de 2 a 3 anos, tem pequeno porte (3 a 5 cm) e quando atinge a fase adulta trabalha com todos os estágios de vida. É dotado de genoma sequenciado (70% de seus genes são semelhantes aos genes humanos).
Ao discorrer sobre as pesquisas voltadas à área de saúde, Mônica citou que, dentre as vantagens da espécie para a tal finalidade, estão a alta taxa de reprodutividade (100 a 200 embriões por dia), o fato de possuir embriões transparentes, o rápido desenvolvimento, além da criação econômica e fácil manipulação genética.
Ao dimensionar a abrangência para os estudos de feita com o Zebrafish, a pesquisadora do Butantan destacou que a espécie serve para estudos em diversas áreas por possuir grande potencial para inúmeras pesquisas.“Já existem pesquisas contemplando algumas áreas como: ecotoxidade; nanopartículas; poluentes ambientais; toxina tetânica; validade de teste toxicológica; estudos de venenos de animais e suas toxinas”, frisou.
No período de 15 a 26 de maio, as pesquisadores Adriana Ximenes, do ICBS, e Aline Fidelis, da Escola de Enfermagem e Farmácia (Esenfar), estarão visitando Instituto Butantan para a realização de experimentos, marcando mais uma etapa no processo inicial de implantação da Plataforma na Universidade Federal de Alagoas.
Ufal integra Rede Nacional de Pesquisa em Biotecnologia Marinha
A BiotecMar é articulada pelo Ministério da Ciência, Tecnologia, Inovações e Comunicações (MCTI)
- Atualizado em

Diana Monteiro - jornalista
A Universidade Federal de Alagoas está entre as doze instituições que participam das pesquisas para estudos inovadores sobre o ambiente marinho da Rede Nacional de Pesquisa em Biotecnologia Marinha (Biotecmar), articulada pelo Ministério da Ciência, Tecnologia, Inovações e Comunicações (MCTI) e lançada no final de 2016. A rede tem como objetivo desenvolver estudos inovadores sobre o ambiente marinho visando colocar o Brasil mais próximo da liderança mundial em tecnologia e bioeconomia marinha nos próximos dez anos.
A BiotecMar é formada por quatro redes de pesquisas que já existiam coordenadas por pesquisadores das universidades federais do Rio Grande do Sul (UFRGS), de Pernambuco (UFPE), e do Rio de Janeiro (UFRJ), além da Universidade do Rio Grande (FURG). Na Ufal os estudos científicos estão sob a coordenação da professora Melissa Fontes Landell, do campus em Maceió e conta com a colaboração do professor Leonardo Broietto, do curso de Biologia do Campus Arapiraca.
Dentro da rede nacional a instituição alagoana integra o subprojeto denominado de Rede Mar Ativo responsável pelas pesquisas com foco na biopropecção de moléculas obtidas por microrganismos marinhos para utilização na indústria farmacêutica. “A proposta é prospectar estes microrganismos, a partir do ambiente marinho, coletados para as pesquisas pela equipe no litoral de Alagoas e, avaliar atividades biológicas como antifúngicas, antiviral e anti-inflamatório, além de estudar a diversidades destes microrganismos e descrever possíveis espécies novas para a ciência”, enfatiza Melissa. Ela acrescenta que a ideia também é ampliar os pontos de coletas, a exemplo da Área de Proteção Ambiental (APA) dos Corais, até o vizinho estado de Pernambuco.
A Rede Mar Ativo tem a coordenação da Universidade Federal do Rio Grande do Sul (UFRGS) e participação também da Universidade Federal de Rondônia (UNIR), assim como da Fundação Oswaldo Cruz (Fiocruz), deste Estado.
Estudo e publicações
Os estudos científicos na Ufal são desenvolvidos no Laboratório de Diversidade Molecular, instalado no Instituto de Ciências Biológicas e da Saúde (ICBS), sob a responsabilidade de Melissa Landell. Conta com participação de alunos da graduação e pós-graduação dos cursos de Biologia e Farmácia. O professor Leonardo Broetto, além de colaborar com as pesquisas, também participa da orientação dos alunos veiculados ao projeto.
Melissa adianta que, dos estudos desenvolvidos, que resultaram da inclusão da Ufal na rede nacional, já houve, até o momento, a publicação de três artigos em revistas científicas de alto impacto internacional na área. São elas: Archives of Microbiology (Alemanha) ; Marine Pollution Bulletin (Inglaterra); e Mycopathologia ( Holanda).
Potencial econômico
No documento de criação da rede nacional é destacado que a vasta área marinha do Brasil, de cerca de 4,5 milhões de metros quadrados, é fonte potencial para a descoberta de novas moléculas e produtos biotecnológicos de grande valor para a economia do país. A possibilidade de atuação compreende diferentes áreas como farmacose bioativos; cosméticos; aquicultura e pesca; energias renováveis; e alimentos. Além das redes em atuação, a BiotecMar visa reunir grupos de pesquisa em biotecnologia marinha de todas as regiões brasileiras.
Ufal seleciona professores substitutos e temporários para os três campi
As inscrições começam no dia 14 pelo site da Copeve
- Atualizado em
Redação Ascom
A Pró-reitoria de Gestão de Pessoas e do Trabalho (Progep) publicou editais para seleção de professores substitutos para os três campi da Ufal. Segundo o Edital nº 13, a maioria das vagas são para cadastro de reserva, mas tem duas vagas imediatas em ampla concorrência para a Faculdade de Economia, Administração e Contabilidade (Feac). Já a Faculdade de Medicina está com dois editais abertos para vagas de professores temporários.
Os pedidos de inscrição deverão ser feitos por meio do site da Copeve, das 17h do dia 14/02 às 11h do dia 24/02. A taxa de inscrição será de noventa reais, devendo ser paga até o último dia do período de inscrições. Cada candidato poderá concorrer a mais de uma vaga, devendo optar por apenas uma delas na hipótese de conflito entre os cronogramas de realização das provas.
Os cronogramas contendo data exata de início do certame, horários e locais de realização da sessão de apuração da prova de títulos serão divulgados no site da Copeve até o dia 22 de fevereiro. Confira todos os editais para seguir as orientações de documentação necessária.
Ufal vai sediar mais uma edição do evento A Universidade encontra a Periferia
O encontro será realizado nos dias 14 e 15 de fevereiro no auditório da Biblioteca
- Atualizado em

Lenilda Luna - jornalista
Nos dias 14 e 15 de fevereiro, será realizada a segunda edição do evento A Universidade encontra a Periferia. A proposta é promover debates entre intelectuais e ativistas das periferias de Maceió, sobre questões como relações sociais e direitos humanos. Além de estudiosos, os artistas da "periferia" foram convidados a tratar de suas experiências nas áreas da cidade mais desassistidas pelo poder público. A programação pode ser consultada em anexo.
O evento é organizado pelo ativista social, Ari Consciência, e pelo professor Fernando Rodrigues, do Instituto de Ciências Sociais (ICS) da Ufal e coordenador do Grupo de Pesquisa Periferia, Afetos e Economia das Simbolizações (Gruppaes). São abordadas questões como Religião, Política, Movimentos Sociais, Música e Universidade. "Quero estimular tanto na graduação em Ciências Sociais quanto no Programa de Pós-graduação em Sociologia o diálogo e o debate com personagens, movimentos, coletivos e organizações que se identificam ou são identificados sob o símbolo periferia", explica o professor.
A primeira edição de A Universidade encontra a Periferia foi realizada em maio do ano passado. Leia aqui.